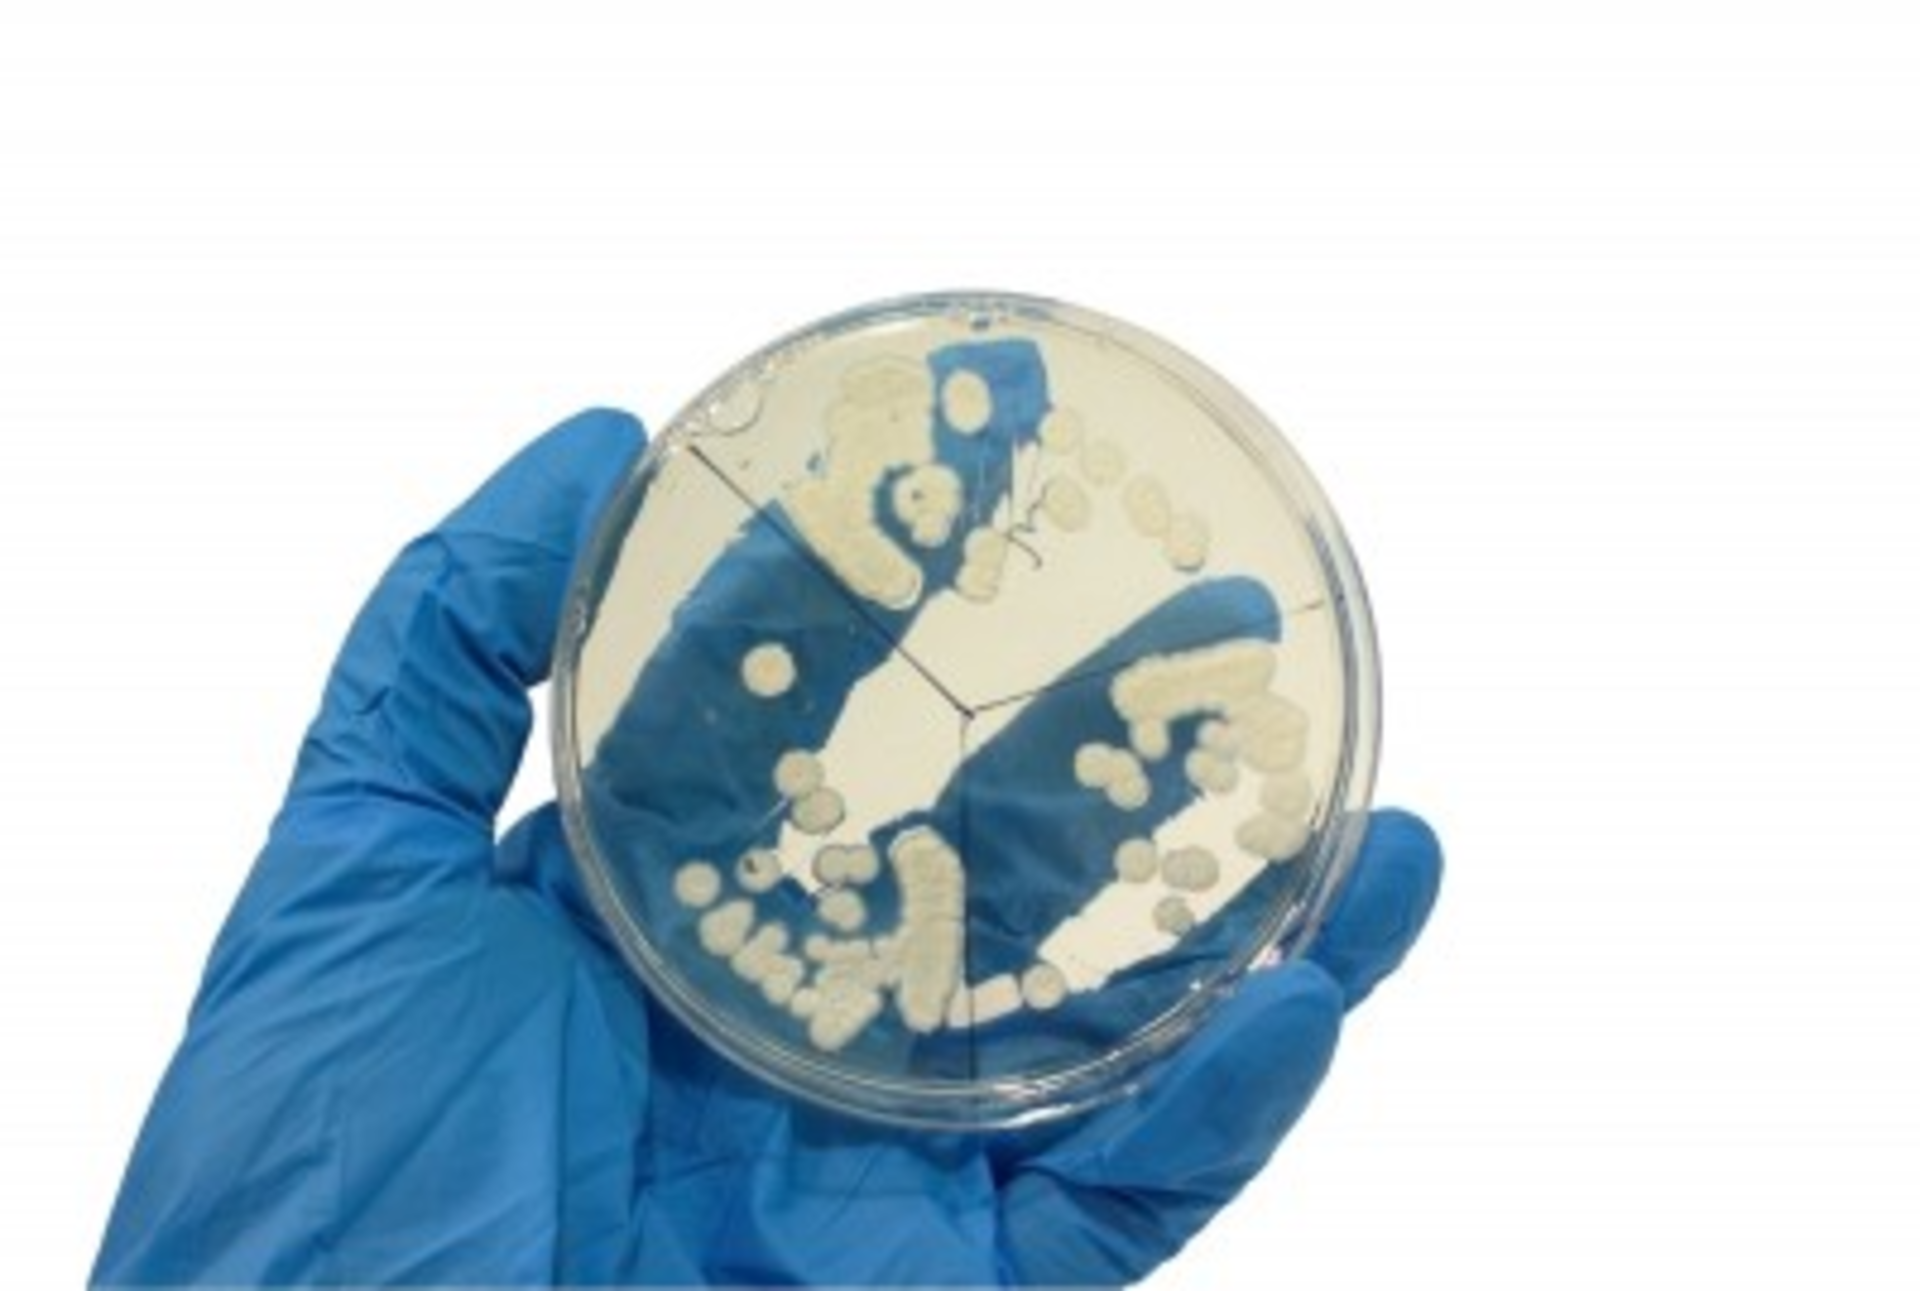
Dirty Hand

“A lot of time incentives are about taking information and using it in a different way. The real hero of this story is the IT staff at the hospital. What they decided to do was make that photograph of the handprint [with the bacteria] the screensaver on every computer in the hospital,” said Dubner. “And they did it, and it worked for whatever reason. Incentives are very hard to predict, what will work and what won’t work. No doc could go on to any floor without seeing that image on multiple computers on the floor. For whatever reason that triggered a change a behavior.”
Hand hygiene soon ratcheted up to 100 percent. Other hospitals saw Cedar-Sinai’s success and even asked to borrow the photograph like it was some magic talisman for hand washing. What Cedars Sinai has subsequently found is that they have had to do a lot to maintain the high rate. The committee continued using negative feedback, in essence shaming physicians into compliance, by posting the name of doctors who had been observed in failing in hand hygiene at departmental meetings. Even if the physician wasn’t at the meeting, undoubtedly, they would get a text from a colleague saying they were on the “crap list.”
“So when you’re dealing with human behavior change, you have to see that even a simple behavior that we can all agree is fruitful, can be much harder to enact than we think,” said Dubner. “That’s why when you’re designing incentives , when you’re trying to change human behavior, often relying on humans to do the change can be fruitless.”
Dubner said that many organizations should focus instead of innovations through technology or design, like in the case of hygiene, investing in antimicrobial surfaces or disposable blood pressure cuffs to stop the spread of germs.
When Dubner was asked about the efficacy of an incentive program like meaningful use, he said that at the core human beings are motivated to benefit themselves and those they care about, rather than benefiting others.
“The problem with the U.S. government in recent history is that it doesn’t have a good track record in creating top-down incentive plans that benefit a lot of people in a system where there are many individual actors,” he said. “The better alternative is experimentation.”